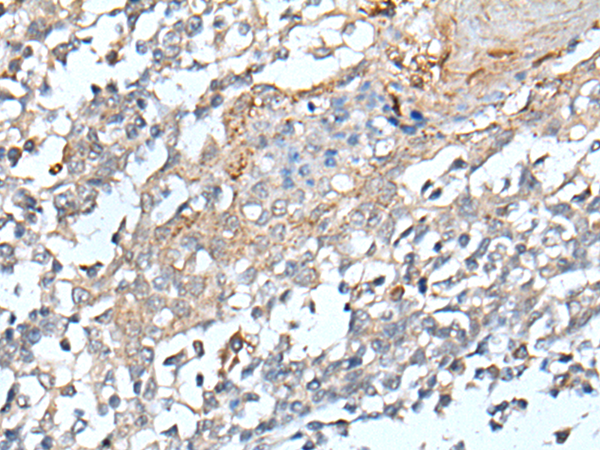

|
Background: |
Cholesterol homeostasis is regulated, at least in part, by sterol regulatory element (SRE)-binding proteins (e.g., SREBP1; MIM 184756) and by liver X receptors (e.g., LXRA; MIM 602423). Upon sterol depletion, LXRs are inactive and SREBPs are cleaved, after which they bind promoter SREs and activate genes involved in cholesterol biosynthesis and uptake. Sterol transport is mediated by vesicles or by soluble protein carriers, such as steroidogenic acute regulatory protein (STAR; MIM 600617). STAR is homologous to a family of proteins containing a 200- to 210-amino acid STAR-related lipid transfer (START) domain, including STARD4 (Soccio et al., 2002 [PubMed 12011452]). |
|
Applications: |
ELISA, WB, IHC |
|
Name of antibody: |
STARD4 |
|
Immunogen: |
Synthetic peptide of human STARD4 |
|
Full name: |
StAR-related lipid transfer domain containing 4 |
|
SwissProt: |
Q96DR4 |
|
ELISA Recommended dilution: |
5000-10000 |
|
IHC positive control: |
Human tonsil |
|
IHC Recommend dilution: |
25-100 |
|
WB Predicted band size: |
24 kDa |
|
WB Positive control: |
Human fetal liver tissue,Mouse liver tissue lysates |
|
WB Recommended dilution: |
200-1000 |
購(gòu)物車(chē)
幫助
021-54845833/15800441009
